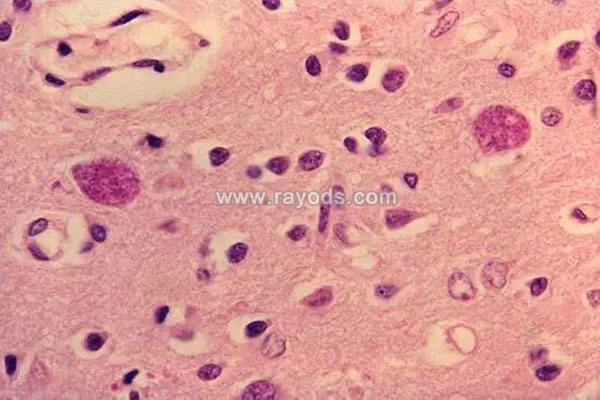

弓形虫抗体igg和igm的区别是什么
- 试管婴儿百科
- 2026-04-17 09:06
在弓形虫检查后拿到结果后可能大多数女性完全弄不懂弓形虫igg和igm是什么意思,虽然感染和未感染就阴性和阳性,但检测结果上为什么会出现弓形虫IgM和弓形虫igg呢?以下本文就为大家详细说明下。
弓形虫igg和igm是什么意思
弓形虫抗体igg和igm的区别是什么
一般来说医生会尤其会提醒饲养宠物的女性在做孕前体检时,一定要做一项弓形虫IgM抗体检查,这将查出有没有感染弓形虫。当弓形虫IgM抗体检查显示已经感染过弓形虫,因为已经产生了抗体就不用担心,但显示从未感染过,则表明没有免疫力就更加需要注意了。
弓形虫检查igg和igm都代表什么
但到做了弓形虫抗体检查拿到检查报告单后往往都会有igg、igm两个数值,这时可能很多人就迷糊了,完全不知道弓形虫igg和igm的区别,其实两者都能检测出是否感染上了弓形虫病,只不过感染的时间不同而已。
1.弓形虫igg
首先要知道弓形虫抗体本身就有igm和igg两型,目前实验室通过间接血凝试验、IFA法和ELISA法测定igg、igm,其参考值均为阴性,代表为感染。但当弓形虫抗体igg阳性时则代表着以往感染过或者现在正处于感染期。
IgG查以前是否感染过弓形虫
2.弓形虫igm
当弓形虫抗体igm结果显示阳性时则代表当前感染上弓形虫,正处于感染期。多数时候感染上弓形虫病的症状并不明显,只能通过实验室检查才能够确诊,而igm呈阳性就是确诊当前感染的铁证。
igm升高是近期感染的指标,igg增高是既往感染的指标。双份血清igg抗体滴度4倍以上增高或单份血清igg抗体滴度1∶512,提示近期感染可能性大。
一般情况下我们到医院检查,没特别要求的情况下,都只是会检测抗体igm,因为igm是反映当前感染情况。呈阴性代表当前没感染,呈阳性代表当时感染中。如果想要看之前到底有没有感染过就必须检查弓形虫抗体igg。

发表评论